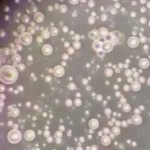
mlijeko

RUSKI LJEKAR PROTIV DIJETA, ŠTETNE SU: Ako želite smršavjeti, slijedite ovu jednostavnu proceduru
“Vjerujem da se kvalitetno gubljenje kilograma bez gubitka mišićne mase može postići kombinacijom različitih vježbi, istezanjem, kao i uravnoteženom prehranom”, govori ruski liječnik Sergej Bubnovski i daje svoje savjete za put do uspjeha.
Što se tiče vježbanja, njegov prijedlog je sljedeći:
Pješačenje: hodajte 2 sata brzinom 6 do 8 kilometara na sat
Trčanje: dovoljno je 20 do 30 minuta, ali da vam otkucaji srca ne prelaze 140-150 otkucaja po minuti
Nordijsko pješačenje: od 3 do 5 kilometara dnevno
Plivanje: bez stajanja barem kilometar i po ili dva kilometra.
Dijeta bilo koje vrste (ako se izuzme ona za dijabetičare ili srčane bolesnike ili dijeta poslije operacije) je štetna, jer prvo gubite mišićnu masu pa tek onda masno tkivo počne polako nestajati.
Zbog toga je neophodno da se hranimo pravilno kako ne bi došlo do određenih bolesti koje nosi i neuhranjenost.
Ovo su pravila dobre prehrane po doktoru Bubnovskom:
1. Jedite prirodnu hranu koja nije obrađena: voće i povrće, orašaste plodove, sir.
2. Odbijajte konzervirane proizvode.
3. Pravite jelo koje sadrži samo 2 do 3 različita sastojka (Hranite se jednostavno i doživjet ćete stotu).
4. Izbjegavajte sol i šećer, zamijenite ih začinima. Sol zamijenite sokom od limuna ili soja sosom, a šećer voćem ili medom.
5. Izbjegavajte alkohol, naročito uz obrok. Vino i voda, konzumirani zajedno s hranom, akumuliraju se u probavnom traktu i rastvaraju enzime koji su neophodni pri razgradnji hrane. Ako popijete čaj nakon jela to će dovesti do debljanja. Umjesto deserta bolje je pojesti lubenicu ili jabuku.
6. Prestanite piti kavu i vidjet ćete kao ćete biti puni energije. Zabuna nastaje kada popijemo kavu i dobijemo nalet energije, ali nakon nekoliko sati osjećamo slabost i glavobolju.
Što se tiče vode: potrebno je piti najmanje 3 litre vode dnevno (12 čaša). Na primjer, ja preferiram ispijanje vode ujutro, prije vježbanja i to se zove unutrašnje tuširanje; zatim pijem vodu odmah nakon vježbanja, prije kupanja, poslije jela, ili sat i pol do dva sata poslije jela. Moramo piti dosta vode. Sastavljeni smo od vode i što je više mijenjamo to se bolje naše tijelo osjeća.
“Ne pijem i ne preporučujem pića iz konzervi kao ni gazirana pića. Najbolje je piti vodu s izvora ili iz bunara (ako znate da je čist), a oni koji pate od osteroporoze i bolesti zglobova ovo pravilo moraju poštovati ako se žele izliječiti.”
( savetdana.com )